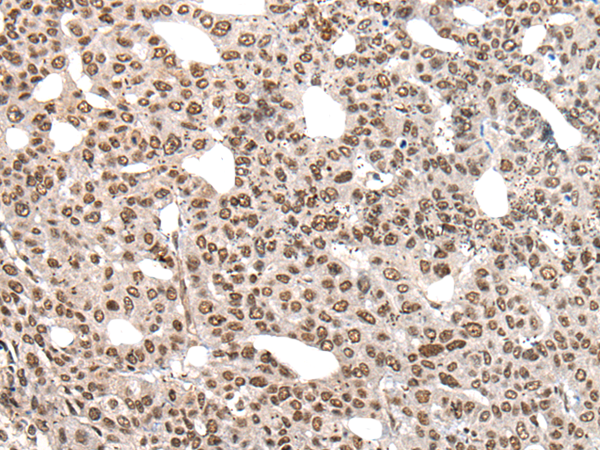

中文名稱: 兔抗HNRNPR多克隆抗體
英文名稱: Anti-HNRNPR rabbit polyclonal antibody
別 名: heterogeneous nuclear ribonucleoprotein R; HNRPR; hnRNP-R
相關類別: 一抗
抗 原: HNRNPR
宿 主: Rabbit
反應種屬: Human
標 記 物: Unconjugate
克隆類型: rabbit polyclonal
Background:
This gene encodes an RNA-binding protein that is a member of the spliceosome C complex, which functions in pre-mRNA processing and transport. The encoded protein also promotes transcription at the c-fos gene. Alternative splicing results in multiple transcript variants. There are pseudogenes for this gene on chromosomes 4, 11, and 10.
Applications:
ELISA, IHC
Name of antibody:
HNRNPR
Immunogen:
Synthetic peptide of human HNRNPR
Full name:
heterogeneous nuclear ribonucleoprotein R
Synonyms:
HNRPR; hnRNP-R
SwissProt:
O43390
ELISA Recommended dilution:
5000-10000
IHC positive control:
Human gastric cancer and human liver cancer
IHC Recommend dilution:
25-100
技術規(guī)格


 購物車
購物車 幫助
幫助
 021-54845833/15800441009
021-54845833/15800441009